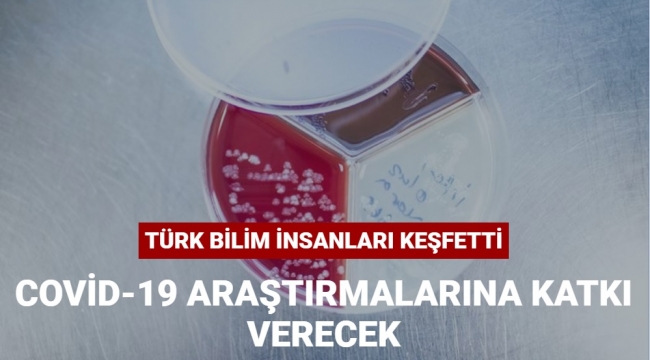

UNAM araştırmacıları, daha önce bilim dünyası için bir sır olan atomlardan insan hücrelerine kadar uzanan bir dizi malzemenin fizik ve matematik kanunları çerçevesinde nasıl bir araya geldiğini ortaya çıkardı.
Bilkent Üniversitesi UNAM araştırmacıları, dünyanın en prestijli bilim dergilerinden Nature Physics'te yayımladıkları makaleyle yeni keşiflerini bilim dünyasına duyurdu.
Serim İlday, keşiflerine ilişkin yaptığı açıklamada, geliştirdikleri metodun biyoteknolojiden nanoteknolojiye birçok alanda devrimsel ilerlemelerin önünü açabileceğini ifade etti.
İlday, geliştirdikleri sistemle canlı insan hücresi ve mikroorganizmayı saniyeler içinde bir yerden bir yere taşıyabildiklerini, karışık halde bulunan bakteri topluluklarını birbirlerinden ayırabildiklerini belirterek, geliştirdikleri algoritmanın Covid-19'la ilgili laboratuvar çalışmalarından yayılım haritalarına kadar pek çok alanda kullanılabileceğini söyledi.
Bilkent Üniversitesi UNAM araştırmacıları, dünyanın en prestijli bilim dergilerinden Nature Physics'te yayımladıkları makaleyle yeni keşiflerini bilim dünyasına duyurdu.
Serim İlday, keşiflerine ilişkin yaptığı açıklamada, geliştirdikleri metodun biyoteknolojiden nanoteknolojiye birçok alanda devrimsel ilerlemelerin önünü açabileceğini ifade etti.
İlday, geliştirdikleri sistemle canlı insan hücresi ve mikroorganizmayı saniyeler içinde bir yerden bir yere taşıyabildiklerini, karışık halde bulunan bakteri topluluklarını birbirlerinden ayırabildiklerini belirterek, geliştirdikleri algoritmanın Covid-19'la ilgili laboratuvar çalışmalarından yayılım haritalarına kadar pek çok alanda kullanılabileceğini söyledi.